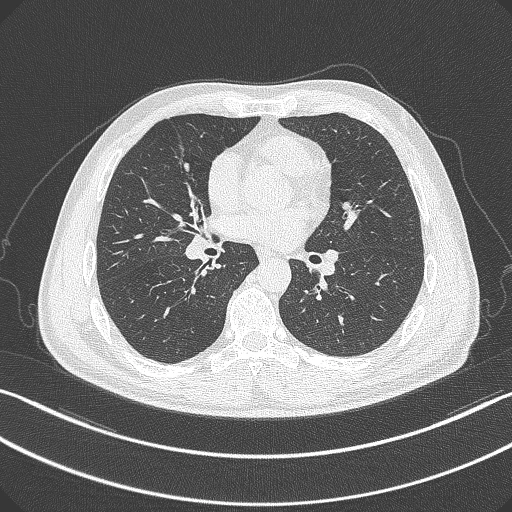

It seems we can add medical imaging to the list of fields about to be revolutionized by artificial intelligence and deep learning computers. A Chinese startup called Infervision has revealed that its intelligent assisted diagnosis software for X-Ray and CT scans has already looked at over 200,000 scans in trials at 20 hospitals around China.
Predominantly used in early-stage lung cancer screening, the system started out with a huge stock of digital health records dating back to 2003 and employed technologies from GE Healthcare, Nvidia and Cisco, as well as more than 50 deep learning algorithms, to refine its diagnosis techniques into a tool it calls AI Scholar.

According to China's Toutiao news site, the Infervision system triples the speed at which radiologists can diagnose CT scans, and has helped reduce the rate of missed cancer diagnoses by some 50 percent.
The company's goal is not to replace doctors or radiologists, but to help them get through what's starting to look like an insurmountable workload. According to Weixin, the amount of medical imaging data is growing by 30 percent per year in China, while the number of radiologists is growing by 4.1 percent, leading to 14-hour work days and stressed out workers.
An AI diagnostic tool that's constantly learning and refining its abilities could cut way down on the repetitive work of trawling through scans, chewing through over 100 high-definition Dicom medical images per second, and letting doctors get to more people.
Source: Infervision via Techcrunch